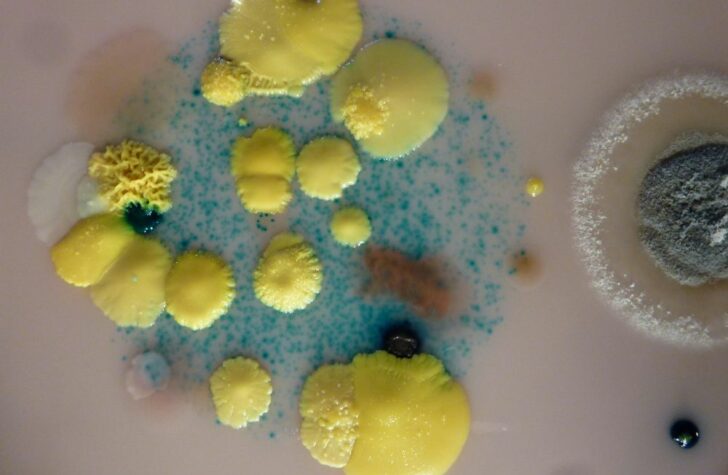

Når mad og videnskab mødes i molekylær gastronomi
Molekylær gastronomi kombinerer madlavning med videnskab og åbner døren til helt nye smagsoplevelser. Det handler ikke kun om avanceret teknik og laboratorielignende udstyr, men om at forstå de kemiske og fysiske processer bag ingredienserne. Ved at udforske, hvordan tekstur, temperatur og kemi påvirker smag, kan kokke skabe retter, der overrasker både syn, smag og sanser. Molekylær gastronomi inspirerer til eksperimenter i køkkenet, hvor traditionelle opskrifter bliver transformeret til kunstværker. Det er både et læringsrum og en legeplads, hvor videnskab og kreativitet mødes på din tallerken.
Principperne bag molekylær gastronomi
Molekylær gastronomi er et område, hvor madlavning og videnskab smelter sammen. Det handler om at forstå, hvordan ingredienser reagerer under forskellige forhold, og bruge den viden til at skabe nye smagsoplevelser og teksturer. I stedet for blot at følge en opskrift, undersøger man de kemiske og fysiske processer, der sker, når man opvarmer, afkøler, blander eller fermenterer mad. Ved at kende disse processer kan man manipulere konsistens, smag og udseende på måder, der tidligere virkede umulige i et almindeligt køkken.
Et centralt aspekt er temperaturkontrol. Mange ingredienser ændrer både struktur og smag afhængigt af varme. Proteinrige fødevarer som æg, fisk eller kød stivner ved forskellige temperaturer, og forståelsen af disse punkter giver mulighed for præcist at tilberede mad med den ønskede tekstur. Selv grøntsager kan ændre smag og farve ved varmebehandling; spinat mister sin friskhed og bliver bitter, hvis den koges for længe, mens blanchering bevarer farve og næringsstoffer.
Et andet vigtigt element er kemiske reaktioner. For eksempel sker Maillard-reaktionen, når proteiner og sukkerstoffer reagerer ved høj varme, hvilket giver stegt kød og brød deres karakteristiske smag og aroma. Ved at kontrollere denne proces kan kokke fremhæve bestemte smagsnuancer og skabe komplekse aromaoplevelser. Ligeledes kan syre, baser og salt påvirke både struktur og smag – en syrlig marinade kan ændre proteiner i kød og fisk, hvilket giver en helt anden konsistens.
Molekylær gastronomi inkluderer også fysiske teknikker som skum, geléer, emulsioner og sfærification. Disse metoder bygger på principper fra kemi og fysik og kan forvandle en almindelig ingrediens til noget uventet. Sfærification, for eksempel, lader væsker blive til små kugler, der sprækker i munden og frigiver smag på en overraskende måde. Skum og emulsioner ændrer mundfornemmelsen og kan fremhæve smagsnuancer uden at tilføje fedt eller sukker.
For at give et klart overblik kan man tænke på molekylær gastronomi som en kombination af tre nøgleområder:
- Kemi: forståelse af hvordan ingredienser reagerer med hinanden.
- Fysik: kontrol af temperatur, tryk og tekstur.
- Sensorik: hvordan smag, aroma og mundfornemmelse opleves.
Ved at kombinere disse områder kan kokke eksperimentere på måder, der udfordrer traditionelle retter og giver gæsterne nye oplevelser. Det handler ikke kun om flotte præsentationer – selv en simpel suppe kan ændre karakter, når man justerer dens tekstur med gelé eller skum. Molekylær gastronomi kræver nysgerrighed, præcision og en villighed til at eksperimentere, men belønningen er en dybere forståelse af madens muligheder og en mulighed for at skabe retter, som engagerer alle sanser.
Teknikker og ingredienser i molekylær gastronomi
Molekylær gastronomi bygger på både klassiske og avancerede teknikker, som ændrer måden, vi oplever mad på. Teknikkerne giver kokke mulighed for at manipulere tekstur, form og smag på måder, der ikke er mulige med traditionel madlavning. Samtidig spiller ingredienserne en central rolle – nogle bruges som bindemidler eller stabilisatorer, mens andre fremhæver smag eller giver visuelle effekter. Kombinationen af de rigtige teknikker og ingredienser er det, der gør molekylær gastronomi til en eksperimenterende og sensorisk oplevelse.
En af de mest kendte teknikker er sfærification, hvor en flydende ingrediens omsluttes af en tynd gelé-hud. Resultatet er små kugler, der eksploderer i munden og frigiver smagen pludseligt. Denne metode bruges ofte til frugtjuice, eddike eller cocktails, men kan også anvendes i supper og saucer for at skabe overraskende effekter. Lignende overraskelser skabes med skum, hvor smagsrige væsker omdannes til lette, luftige skyer ved hjælp af lecithin eller andre emulgatorer. Skum ændrer ikke kun udseendet, men giver en ny mundfornemmelse, der fremhæver aroma og intensitet.
Geléer og stivelsesbaserede strukturer er en anden vigtig teknik. Ved hjælp af agar-agar, gelatine eller pektin kan væsker forvandles til faste eller halvfaste teksturer, der kan formes eller skæres. Dette giver kokke mulighed for at præsentere ingredienser på en ny måde, som overrasker øjet og ændrer, hvordan maden føles i munden. Emulsioner, derimod, kombinerer normalt ublandbare væsker som olie og vand, og skaber cremede saucer eller dressinger med en jævn konsistens.
Ingredienserne i molekylær gastronomi er ofte naturlige stoffer med specifikke egenskaber, som hjælper med at manipulere tekstur og stabilitet. Eksempler inkluderer:
- Lecithin: emulgator, skaber skum og stabiliserer blandinger
- Agar-agar og gelatine: gelering af væsker
- Xanthan gum: fortykningsmiddel, giver struktur uden varmebehandling
- Nitrogen: ekstrem afkøling og dramatisk visuel effekt
Udover teknikker og ingredienser er præcision afgørende. Temperatur, tid og mængder skal måles nøje for at opnå det ønskede resultat. Selv små ændringer kan påvirke både konsistens og smag. For eksempel kan et forkert forhold mellem væske og geléstof resultere i enten en for blød kugle, der brister for tidligt, eller en for hård kugle, som mister den ønskede mundoplevelse.
Molekylær gastronomi er altså både håndværk og eksperiment. Teknikker som skum, sfærer og geléer kombineres med ingredienser, der har specifikke kemiske egenskaber, og skaber retter, som udfordrer forventningerne til både smag, form og tekstur. Det giver mulighed for at lege med sanserne og overrasker gæsterne på måder, traditionelle retter sjældent gør.
Smagsoplevelser og kreative muligheder
Molekylær gastronomi åbner døren til en helt ny verden af smagsoplevelser, hvor tekstur, aroma og visuel præsentation går hånd i hånd. I stedet for at spise ingredienser i deres traditionelle form kan du opleve mad på måder, der overrasker sanserne. En skefuld suppe kan pludselig blive til små kugler, der eksploderer i munden, eller en klassisk dessert kan fremstå som et luftigt skum med intens smag. Det handler om at eksperimentere med sanserne og skabe øjeblikke, der giver både overraskelse og glæde.
En vigtig del af oplevelsen er kontraster i tekstur. Ved at kombinere bløde, sprøde, cremede eller flydende elementer på samme tallerken kan kokke lede smagsoplevelsen og stimulere sanserne på nye måder. For eksempel kan en dessert bestå af en sprød kagebund, et cremet fyld og en flydende frugtsfære, som hver især giver en forskellig følelse i munden. Kontrasterne gør retten mere interessant og engagerer smagsløgene, fordi hver bid bliver en ny oplevelse.
Farve og visuel præsentation er også centralt i molekylær gastronomi. Retter kan transformeres til små kunstværker, hvor farver og former spiller sammen med smagen. Dette påvirker oplevelsen direkte, fordi hjernen ofte forbinder farve og udseende med forventet smag. Når en ret ser spændende ud, bliver smagsoplevelsen ofte mere intens, og det skaber et stærkere sansemæssigt indtryk.
En anden kreativ mulighed er smagskombinationer, der udfordrer forventninger. Molekylær gastronomi gør det muligt at kombinere ingredienser, som normalt ikke ville mødes. En skarp citrus kan balanceres med sødme fra en flydende gelé, eller salt og chokolade kan sammensættes på overraskende måder. Dette eksperimentelle element er med til at gøre molekylær gastronomi til en legende tilgang til mad, hvor både kok og gæst kan opdage nye smagsnuancer.
Et eksempel på, hvordan man kan tænke sanser og smag sammen, kan illustreres med følgende principper:
- Tekstur: blød, sprød, cremet, flydende
- Smag: syrlig, sød, salt, bitter, umami
- Visuel effekt: farve, form, præsentation
- Overraskelse: hvordan elementerne ændres under måltidet
Når man kombinerer disse elementer, bliver måltidet mere end blot ernæring – det bliver en oplevelse. Molekylær gastronomi inviterer dig til at udforske, hvordan smag, konsistens og udseende kan arbejde sammen for at skabe øjeblikke, som engagerer flere sanser samtidigt.
Det kreative potentiale i molekylær gastronomi er stort. Teknikker som skum, sfærification og geléer giver mulighed for at omdanne velkendte retter til noget helt nyt. Selv simple ingredienser som æg, mælk eller frugt kan forvandles til uventede teksturer og smagsoplevelser. Det betyder, at du kan lege med klassiske opskrifter, tilføje overraskelsesmoment og skabe retter, som gæsterne husker længe efter måltidet.
Molekylær gastronomi handler altså ikke kun om teknik, men om at udforske madens kreative potentiale. Ved at kombinere videnskab, præcision og fantasi kan du skabe oplevelser, der engagerer både smag, syn og følelse, og som gør hver ret til en lille opdagelsesrejse.
Molekylær gastronomi viser, hvordan videnskab og kreativitet kan forvandle måltider til oplevelser for alle sanser. Det handler ikke om at følge komplekse opskrifter slavisk, men om at lege med tekstur, smag og præsentation. Ved at forstå ingrediensernes kemi og fysik kan du skabe overraskelser på tallerkenen, udfordre forventninger og opdage nye måder at nyde mad på. Molekylær gastronomi er både læring og leg – og den giver dig mulighed for at opleve, hvordan mad kan fascinere, inspirere og overraske på samme tid.

















